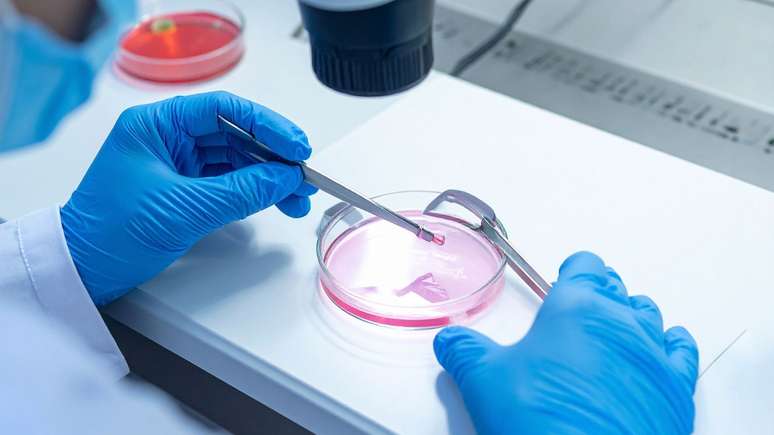

Congelar óvulos garante a maternidade no futuro? Especialista faz alerta importante
Entenda por que o congelamento de óvulos é uma ferramenta de liberdade, mas não deve ser encarado como uma garantia absoluta
Congelar óvulos não é uma garantia de gravidez no futuro, mas sim a preservação de uma oportunidade biológica. Muitas mulheres buscam o procedimento como uma forma de "ganhar tempo" diante das pressões da carreira ou da falta de um parceiro ideal. Segundo o ginecologista Dr. Vinicius Bassega, o método amplia as chances de sucesso, desde que a paciente tenha expectativas realistas. Ele explica que "o procedimento costuma fazer sentido quando a mulher deseja preservar sua fertilidade para o futuro, sabendo que a idade tem impacto direto na quantidade e principalmente na qualidade dos óvulos".
A vantagem da idade biológica
O grande trunfo dessa tecnologia é permitir que os óvulos mantenham a saúde do momento em que foram coletados. Se uma mulher realiza o congelamento aos 30 anos e decide engravidar aos 40, o material genético preservado terá o vigor da juventude. O especialista esclarece que "o congelamento preserva óvulos com a idade biológica do momento em que foram coletados". Essa diferença é crucial, pois a fertilidade feminina naturalmente diminui com o avançar dos anos. No entanto, o médico reforça que existem variáveis externas, como fatores uterinos, que também influenciam o resultado final.
Expectativa versus realidade no consultório
É fundamental desmistificar a ideia de que o congelamento funciona como um "seguro-maternidade" infalível. Na prática médica, o sucesso depende do número de óvulos obtidos e da reserva ovariana da paciente no ato da coleta. O especialista faz um alerta direto sobre a ilusão de certeza absoluta. De acordo com Bassega, "o procedimento preserva uma possibilidade, não uma certeza". O acompanhamento individualizado serve para alinhar o que a ciência pode oferecer com os planos de vida reais de cada mulher.
A decisão de passar pelo processo deve ser baseada em informação de qualidade e consciência do momento atual. Para algumas mulheres, essa estratégia traz paz de espírito; para outras, pode não ser o caminho ideal. Como define o médico, "a vida reprodutiva não funciona dessa forma. O mais importante é que a decisão venha de informação de qualidade, avaliação individualizada e consciência do próprio momento de vida". No fim, o mais importante é que a maternidade seja uma escolha construída no tempo de cada mulher.

Comentários
As opiniões expressas nos comentários são de responsabilidade exclusiva de seus autores e não representam a opinião do Terra.